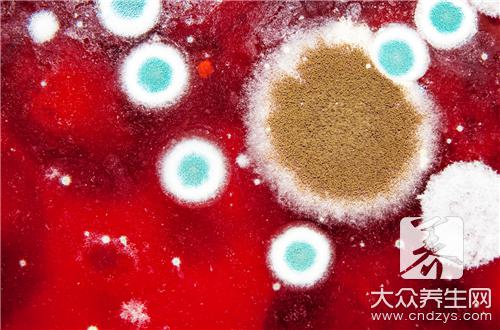
霉菌吸入鼻腔会怎么样,霉菌吸入过多的症状

霉菌是一种真菌,这种真菌会感染人体的很多部位,引起不同的疾病,比如大家熟知的霉菌性阴道炎,这就是发病率非常高的一种妇科疾病,很多病毒和细菌都是从人的口进入的,如果不小心吸入霉菌的话,可能会感染呼吸道,从而导致呼吸道炎症,然后患者会出现下列症状。
霉菌吸入呼吸道症状?
普通正常人有一系列的自身防护机制防止呼吸中吸入异物、病源体。
指导意见:
大多数人在这种情況下不会有任何病变发生的。当然感染的机会还是有的,肺部霉菌感染会引发肺炎,建议以后再进行相关工作时配带N95或以上级別的口罩,感少吸入

处理了一批的大量霉菌的橙子,也修了不少霉菌建议应该保持室内空气流通,多吃润喉润肺的食物,帮助排出霉菌
因处理了一批带有大量霉菌的橙子,吸入了不少霉菌到呼吸道内,咨询吸入霉菌对身体有无害处。
指导意见:
指导意见:1.在处理带有大量霉菌的橙子过程中,应带口罩,以减少霉菌的吸入。2.吸入到呼吸道的霉菌,绝大部分通过呼吸道上皮纤毛运动、咳痰,排出体外,极少数霉菌即使进入血液,人体有自身免疫力,把它清除掉。3.长期吸入,因人体清除能力是有限的,危害就会显现出来。
有肺炎的可能建议服用苄星青霉素治疗。

建议平时多吃些有营养容易消化的食物,注意饮食搭配,少吃油炸的东西,少吃多餐,生活上注意不要太过劳累,注意休息。
霉菌感染是引起肺炎的病因之一,但是就描述的情况,一般并不会感染肺炎。
指导意见:
尽管这不是肺炎的病因,但是对身体还是有一定危害的,建议戴口罩做这些事情,以免吸入霉菌。
搞卫生时吸入较多带有霉菌的粉尘,不要紧的,但是一般不会对人体造成伤害.。霉菌是条件致病菌,空气中就有大量的细菌,没事。